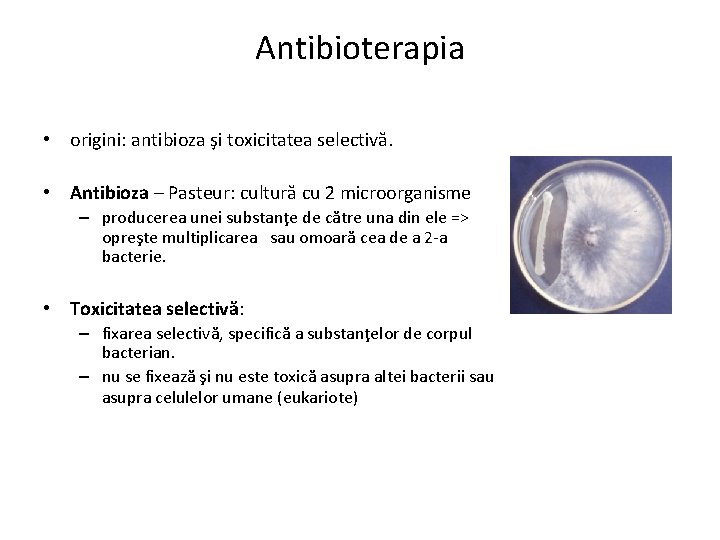
Antibioterapia • origini: antibioza şi toxicitatea selectivă. • Antibioza – Pasteur: cultură cu 2

Antibiotice Dr Carmen Costache Antibiotice Planul cursului Definiie

Antibiotice Dr. Carmen Costache

Antibiotice Planul cursului • Definiţie – Antibiotice vs Chimioterapice – Antibiotice vs Antiseptice • Clasificare – Spectru de acţiune – Tipuri de efect antibacterian • Combinatii de AB • Farmacocinetica • Familii de antibiotice – Mecanisme de acţiune • Rezistenţa la antibiotice

Antibiotice / chimioterapice • Antibioticele (AB): – substanţe naturale, cu efect antibacterian, produse de microorganisme. • Chimioterapicele (CH) : – substanţe chimice cu efect antibacterian. Datorită apariţiei rezistenţei bacteriene: => modificarea structurii antibioticelor de bază dintr-o familie, => derivaţii semisintetici ai antibioticelor. • AB/CH diferite după • provenienţa, • mod de producere, • dar au acelaşi efect.

Antibiotic Penicillin Cephalosporin Griseofulvin Organisms Penicillium chrysogenum Cephalosporium acremonium Penicillium griseofulvum Bacitracin Bacillus subtilis Polymyxin B Bacillus polymyxa Amphotericin B Streptomyces nodosus Erythromycin Streptomyces erythreus Neomycin Streptomyces fradiae Streptomycin Streptomyces griseus Tetracycline Streptomyces rimosus Vancomycin Streptomyces orientalis Gentamicin Rifamycin Micromonospora purpurea Streptomyces mediterranei Penicillium Cephalosporium Streptomyces griseus
Antibioterapia • origini: antibioza şi toxicitatea selectivă. • Antibioza – Pasteur: cultură cu 2 microorganisme – producerea unei substanţe de către una din ele => opreşte multiplicarea sau omoară cea de a 2 -a bacterie. • Toxicitatea selectivă: – fixarea selectivă, specifică a substanţelor de corpul bacterian. – nu se fixează şi nu este toxică asupra altei bacterii sau asupra celulelor umane (eukariote)

DezinfectanteAntiseptice • substanţe cu efect antibacterian, • active în concentraţii mari • NU respectă principiul toxicităţii selective. • se utilizează doar extern => – îndepărtarea microorganismelor de pe suprafeţe

Indicele terapeutic • IT = Doza toxica/doza efectiva. • Cu cat IT mai mare, cu atat AB este mai bun !

Spectrul de acţiune al unui antibiotic • totalitatea genurilor şi speciilor bacteriene asupra cărora acţionează antibioticul: – – – coci Gram pozitivi şi negativi, bacili Gram pozitivi şi negativi, bacterii anaerobe, spirochete, Mycobacterii, bacteri cu patogenitate intracelulară: • Richettsia, Chlamydia, Mycoplasma.

Spectrul de acţiune al unui antibiotic • Spectru îngust => specie bacteriena • ex. antibioticele antistafilococice, Tuberculostatice • Spectru restrâns => număr mic de grupe, genuri bacteriene: – Ex. Acid nalidixic - activ doar pe bacili Gram negativi • Specru larg = active asupra majorităţii genurilor, speciilor bacteriene: • Spectru ultralarg: active asupra bacteriilor din mediul spitalicesc, multiplu rezistente la antibiotice. Antibiotic Spectrum Penicillin Gram-positive bacteria Bacitracin Gram-positive bacteria Vancomycin Gram-positive bacteria Polymyxin B Gram-negative bacteria Streptomycin Gram-negative bacteria Gram-positive Erythromycin negative cocci; some Gram negative bacilli Neomycin Broad-spectrum Tetracycline Broad-spectrum Cephalosporin Broad-spectrum Gentamicin Broad-spectrum Rifamycin Tuberculosis

Spectrul de acţiune al unui antibiotic

Efect antibacterian • Bacteriostatic: opresc multiplicarea • ex. Cicline (ex. Tetracicline), Cloramfenicol • Bactericide: omoară bacteriile, în concentraţii mici; • ex. Aminozide • Bacteristatice în concentraţii mici şi bactericide în concentraţii mari; • ex ß –lactamine

Combinatii de AB • Sinergism • Antagonism • Indiferenta



Farmacocinetica unui antibiotic • In vitro ≠ in vivo • Localizarea infectiei – Capacitatea AB de a ajunge la situsul infectiei • Influentata de cinetica AB = disponbilitatea biologica – Intracelular, puroi, bariera hematoencefalica • Tipul infectiei • Inactivarea AB: – p. H, – Tesut necrotic • Rezistenta bacteriei la AB exprimata in vivo (inductie)

Farmacocinetica unui antibiotic • pătrunderea antibioticelor în organism: – calea de administrare: orală – parenterală: intravenoasă, intramusculară, subcutanată • Infectii severe, sistemice – Externa: crème, unguente, solutii (picaturi nazale, oftalmice) • absorbţia antibioticelor: rapidă, lentă • metabolizarea antibioticelor

Farmacocinetica unui antibiotic • distribuţia în organism: în ţesuturi, organe, penetrarea barierei hematoencefalice, penetrarea intracelulară. • toxicitatea antibioticelor (hepatică, renală, medulară, nervoasă, etc) • calea de eliminare a antibioticelor: urinară, digestivă

Farmacocinetica unui antibiotic

Condiţii pentru un AB să fie activ • să ajungă la bacterie • să pătrundă în bacterie – să fie permeabilă pentru antibiotice – să dispună de un transportor pentru antibioticul respectiv • să atingă ţinta de acţiune • să realizeze în bacterie o concentraţie optimă, care să inactiveze reversibil sau ireversibil ţinta de acţiune.

Tratamentul cu antibiotice

Familii de antibiotice • AB care au • structură chimică, • ţintă de acţiune • mecanism de acţiune comune.

Tinta de actiune – nivel molecular Structura/functie inactivata ireversibil/reversibil de catre AB

Ţinte ale antibioticelor • Perete celular: – ß Lactamine – Glicopeptide: Vancomicina, Teicoplanina • Ristocetina – Fosfomicina, Cicloserina, Bacitracina, • Membrana citoplasmatică: – Polipeptide ciclice: ex. Colistin, polimixina B – Gramicidina, Tirociclina, Defensine, L - Antibiotice

Ţinte ale antibioticelor • Acizi nucleici: – – Quinolone, Imidazoli, Furani, Rifamicine • Ribozomi: AB care inhibă sinteza proteică – 30 S: Aminoglicozide, Tetracicline, Spectinomicine – 50 S: grupul MLS , Fenicoli • Macrolide, Lincosamide, Sinergistine – Acid fusidic: factorul de elongare (EF)

Ţinte ale antibioticelor • Inhibǎ sinteza acidului folic: • Diaminopirimidine • inhiba folat reductaza: Trimetoprim • Pirimetamina • Sulfonamide • Inhiba folat sintetaza: Sulfametoxazol Asocierea Trimetoprim + Sulfametoxazol = Co-trim-oxazol (Biseptol) – Sulfone: Dapsone – PAS (acid paraaminosalicilic)

Familii de Antibiotice • • • • β Lactamine, • grup Monobactam şi gamma (γ) Lactamine Aminoglicozide grup MLS: • Macrolide, Lincosamide, Sinergistine Tetraclicline Fenicoli Quinolone Sulfamide Polipeptide ciclice, Glicopeptide Sulfamide Imidazoli Furani Rifamicine Tuberculostatice AB neîncadrate în familii: • Fosfomicina, Cicloserina, Novobiocina, Acid fusidic,

AB => peretele celular - ß Lactamine • inhibă sinteza peptidoglicanului – în faza de polimerizare. • ţintă de acţiune: PBP-uri – inhibată funcţia enzimatică : transpeptidarea, transglicozidarea, carboxipeptidarea • inelul ß lactam = analog structural al legăturii sterice D Ala - D Ala.

Rezistenţa la β-Lactamine 1. Modificarea permeabilităţii bacteriene 2. Modificarea ţintei (PBP) 3. Inactivarea prin β-lactamaze 1. Penicilinaze 2. Cefalosporinaze 3. BLSL 4. BLSE 4. Pompe de eflux

Familia β-Lactaminelor Grup I: Derivaţi ai acidului 6 -aminopenicilinic 1. Penami (peniciline) 2. Carbapenemi 3. Oxapenami (Clavani)

Familia β-Lactamine Grup II - Cefalosporine derivati de acid 7 aminocefalosporanic Primele izolate din tulpini de Cephalosporium (fung filamentos) Aceeşi acţiune ca şi Penicilinele Diferite generatii

Familia β-Lactaminelor- Peniciline (Penami) a) peniciline cu spectru îngust (Penicilină G şi Penicilină V) coci Gram pozitivi şi negativ, bacili Gram + şi spirochete Penicilina G adm. parenterala Penicilina V administrare p. o. Reactii alergice ! Peniciline semiretard şi retard: Propicilina; Procain Penicilină = Efitard; Benzantin Penicilină = Moldamin • b) peniciline rezistente la penicilinaze - Peniciline M • Meticilină • Oxacilină • Pentru tratamentul infecţiilor cu stafilococi. • MRSA = methicillin resistant Staphylococcus aureus

Familia β-Lactaminelor- Peniciline (Penami) c) peniciline cu spectru larg : Amino peniciline Ampicilină – şi bacili Gram negativi (NU Pseudomonas) Amoxicilină – şi unii bacili Gram negativi (NU Pseudomonas) Carboxy peniciline Carbenicilină, Ticarcilină şi bacili Gram negativi, inclusiv Pseudomonas Ureidopeniciline Piperacilină

Familia β-Lactaminelor- Peniciline (Penami) d) Inhibitori de β-lactamaze – penicilin sulfone Ø Sulbactam, Ø Tazobactam In combinaţie cu Peniciline cu spectru larg • • • Sulbactam + Ampicilină = Sultacilină (Unasyn) Sulbactam + Becampicilină = Sultamicillină; Tazobactam + Piperacilina = Tazocin

Familia β-Lactamine 2. Carbapenemi • Imipenem, Meropenem – – Spectru larg de acţiune Bactericid, bacterii Gram + şi –, anaerobi. • 3. Oxapenemi sau Clavami • acid clavulanic = inhibitor de β-lactamaze – + peniciline cu spectru larg (Amoxicilină, Ticarcilină) – ex. Amoxicilină + acid clavulanic = Augmentin®

Familia β-Lactamine – Cefalosporine Generaţia I Cefalexin, Cefalotin, Cefazolin Spectru îngust - E. coli, Klebsiella, Proteus şi Gram + coci sensibili la Oxacilină. • Generaţia a II-a • Cefuroxim, Cefoxitin - Spectru extins bacterii Gram – , unii anaerobi

Familia β-Lactamine – Cefalosporine Generaţia a III-a Cefotaxim, Ceftazidim spectru larg, Enterobacteriaceae şi Pseudomonas aeruginosa • Generaţia a IV-a Cefepime, Cefpirom - Spectru extins : Pseudomonas, alţi bacili Gram negativi, coci Gram pozitivi - Traversează bariera hemato-encefalică

Familia β-Lactamine - GRUP III Grup III Monobactami - Aztreonam - Spectru îngust - Pseudomonas aeruginosa.

Familia γ LACTAMINE • asemănătoare ß lactaminelor. • Reprezentanţi: Pirazolidinon,

Alte AB => peretelui celular bacterian FOSFOMICINA • Spectru de acţiune: îngust, – coci Gram + si MRSA, unii coci Gram (-). – bună difuzie în LCR. • bacteriostatic. BACITRACINĂ • Spectru de acţiune: îngust: doar pe bacteriile Gram pozitive. • Ţinta de acţiune: Bactoprenolul - inhibă reciclarea. • Toxicitate: crescută => Administrare: locală CICLOSERINĂ • Spectru de acţiune: Tuberculostatic

AB care acţionează la nivelul peretelui celular bacterian Glicopeptide: Vancomicină (activa pe MRSA), Teicoplanină

Polimixine • • • AB izolate din Bacillus polymyxa Polimixină B distrug membrana citoplasmatică efect bactericid spectru îngust Doar bacterii Gram –, mai ales Pseudomonas aeruginosa

AB care acţionează la nivelul acizilor nucleici bacterieni Quinolone Imidazoli Furani Rifamicine

Quinolone • • inhibă sinteza ADN bacterian bactericid Bacterii Gram + şi Gram – Acid nalidixic, Ciprofloxacină, Norfloxacină, Ofloxacină

Inhibarea sintezei ADN bacterian Nitrofurani • Metronidazol • Spectru larg • Bacteriostatic/bactericida – ~ doză • Nitrofurantoin, Furazolidon • bactericid • bacterii anaerobe – Bacteroides fragilis – Clostridium • Protozoare: – Trichomonas vaginalis – amebiaza, – giardiaza

AB care inhibă sinteza proteică bacteriană • Ribozomi: sediul sintezei proteice – 30 S 50 S • Aminoglicozide, • Tetracicline, » Acid fusidic grupul MLS Fenicoli

Aminoglicozide • • bactericide spectru larg: bacili Gram negativi inhibirea sintezei proteice: subunitatea ribozomală 30 S Streptomicină, Kanamicină, Gentamicină, Amikacină

Tetracicline • • • spectru larg, bacteriostatic inhibirea sintezei proteice: subunitatea ribozomală 30 S coci Gram + şi –, bacili Gram + Chlamydia, Mycoplasma şi Rickettsia • Tetraciclină, Doxiciclină, Minociclină

Cloramfenicol • spectru larg • inhibirea sintezei proteice: subunitatea ribozomală 50 S • De elecţie pentru febra tifoidă (bacteriostatic pentru Salmonella) • Bactericid: Neisseria meningitidis, Streptococcus pneumoniae şi Haemophilus influenzae • Efecte adverse numeroase

Macrolide • • • inhibirea sintezei proteice: subunitatea ribozomală 50 S Spectru larg coci Gram (+) şi (–), bacili Gram (+) Mycoplasma, Legionella, Chlamydia, Campylobacter , Helicobacter pacienţi alergici la Penicilină Eritromicină, Azitromicină, Claritromicină Lincosamine • Acţionează pe subunitatea ribozomală 50 S • Clindamicină, Lincomicină • bacterii Gram + şi Gram – anaerobe: (Clostridium perfringens, Bacteroides fragilis)

Oxazolidine • • • Linezolid Spectru îngust DOAR bacterii G +, – VRE, MRSA • Subunitatea ribozomală 50 S

Antibiotice antituberculoase • • • Rifampicină Izoniazidă Pirazinamidă Etambutol Streptomicină

AB care inhibă sinteza acidului folic • Sulfamide, Trimetoprim

Rezistenţa bacteriilor la antibiotice • Definiţie – Bacterii rezistente = bacteriile care supravieţuiesc la concentraţii mari de antibiotic, mult mai mari decât cele din organismul uman. • Naturală • Dobândită

Rezistenţa bacteriilor la antibiotice Naturală - caracter de specie 1. Absenţa ţintei de acţiune – Ex. Mycoplasma rezistentă la β-lactamine • NU are perete celular. 2. Impermeabilitatea bacteriei pentru antibiotic – Ex. Mycobacterium Dobândită: când o tulpină bacteriană anterior sensibilă la un anumit antibiotic devine rezistentă • Caracter de tulpină • Ex. Staphylococcus aureus – anterior sensibil la Penicilină, – În prezent 90% dintre tulpinile de Sa = tulpini rezistente la Penicilină

Rezistenţa bacteriilor la antibiotice Mecanisme genetice • Rezistenţa apare indiferent de antibiotic • rolul antibioticelor : selecţie a tulpinilor rezistente. • mecanisme cromozomiale – Mutaţii => mutante rezistente => clonă mutantă

TIPURI DE MUTANTE Mutante de rezistenţă la antibiotice

Rezistenţa bacteriilor la antibiotice Mecanisme genetice • mecanisme extra-cromozomiale – Achiziţia de material genetic extracromozomial – Ex. ” plasmide R “

Rezistenţa bacteriilor la antibiotice Mecanisme • modificarea permeabilităţii bacteriene • modificarea transportului antibioticului in bacterie • modificarea ţintei • Enzime de inactivare a antibioticului • Activarea pompelor de eflux • Combinaţii ale acestor mecanisme.

Rezistenţa bacteriilor la antibiotice

Rezistenţa bacteriilor la antibiotice


Testarea sensibilităţii bacteriilor la antibiotice Antibiograma • Determinarea sensibilitatii/rezistentei bacteriilor la antibiotice • Efect bacteriostatic • Efect bactericid

Testarea sensibilităţii bacteriilor la antibiotice Antibiograma • !!! Orice infectie bacteriana va fi tratata numai dupa identificarea bacteriei si efectuarea antibiogramei • Metode: » Metoda dilutiilor » Metoda difuzimetrica » E-test

Antibiograma Metoda dilutiilor • Medii de cultura lichide • Dilutii de antibiotic intr-un mediu de cultura favorabil dezvoltarii bacteriilor • Cantitati egale din cultura bacteriana testata • Incubare • Metoda de referinţă • Avantaj major: determinarea valorii concentraţie minime inhibitorii (CMI)


Antibiograma - Metoda diluţiilor Citire si interpretare Mediu de cultura clar, limpede tulbure Se stabileste CMI (concentraţia minimă inhibitorie) CMI – valoare diferită pentru fiecare bacterie şi antibiotic

Antibiograma Metoda dilutiilor !!!!! Reducerea timpului de citire al rezultatelor: Indicator de p. H (virarea culorii mediului apare mai rapid decat tulburarea lui)

Antibiograma Metoda difuzimetrică v Medii de cultura solide - Mueller Hinton v AB depuse pe placa însămânţată cu tulpina bacteriană difuzează în mediu v Se măsoară DIAMETRUL ZONEI DE INHIBIŢIE (mm) v Rezultatul se compară cu tabele standard

Testarea sensibilităţii la antibiotice

Antibiograma prin metoda difuzimetrică Tehnica de lucru • După identificarea şi izolarea tulpinii bacteriene • Se însămânţează cultura bacteriană (se prepară în prealabil o suspensie bacteriană=> trebuie sa aiba o anumita densitate) • Se însămânţează “în pânză” • Pe suprafata placii se depun AB (rondele/ microcomprimate) • Termostat (24 -48 h) • Interpretare

Antibiograma prin metoda difuzimetrică Interpretarea rezultatelor • Cu o rigla se masoara diametrul zonei de inhibitie a dezvoltarii bacteriene (exprimat in mm) • Se compara cu datele din tabelele standard • Rezultatele se exprima: » Sensibil (S) » Intermediar sensibil (IS) » Rezistent (R)

Antibiograma E-testul • Combina avantajele cele doua metode • Medii de cultura solide • Benzi impregnate cu AB în concentraţii descrescătoare • !!! Citire: locul în care zona de inhibitie intersectează banda = CMI

• Medii cu sange- pt. streptococi • Lowenstein-Jensen- pt. bacilul TBC • Pt anaerobi • !!Se pot studia efectele asocierilor de antibiotice

REZISTENŢA CLINICĂ = MULTIFACTORIALĂ PACIENT -STATUS IMUNITAR -SITUSUL INFECTIEI -DISPOZITIVE MEDICALE -CONTROL INEFICIENT MICROORGANISM -REZISTENTA MICROBIOLOGICA -PRODUCEREA DE BIOFILM -DENSITATEA INOCULULUI ESEC TERAPEUTIC ANTIBIOTIC/CHIMIOTERAPIC - ACTIUNE - POSOLOGIE - FARMACOCINETICA - INTERACTIUNI MEDICAMENTOASE

Rezistenţa bacteriilor la antibiotice
- Slides: 75